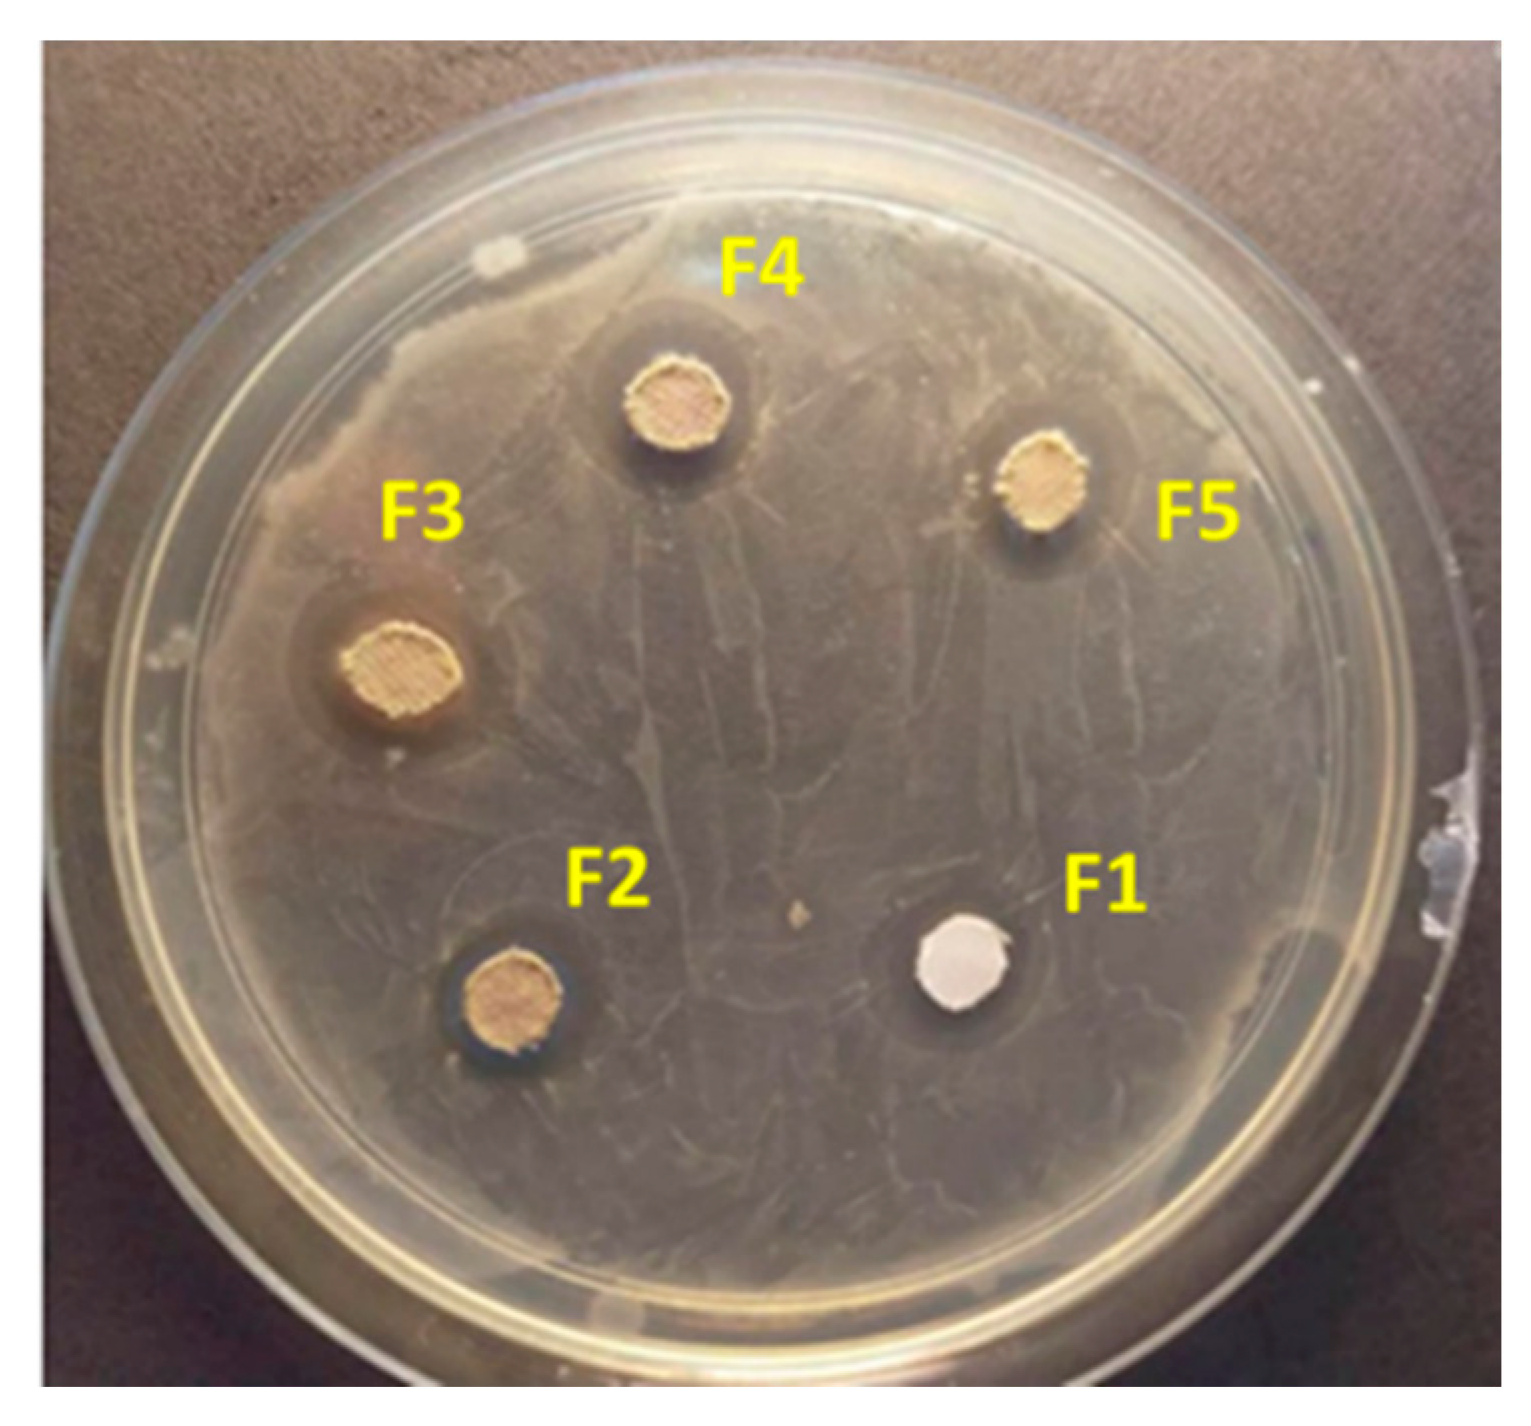
Nanomaterials 09 00450 g006

Synthesis, Characterization, and Antibacterial Activity of Ag2O-Loaded Polyethylene Terephthalate Fabric via Ultrasonic Method
Abstract
:1. Introduction
2. Materials and Methods
3. Results and Discussion
3.1. X-ray Diffraction Analysis
3.2. Microstructural Observation
3.3. FTIR Results
3.4. UV–Vis Tests
3.5. Wettability Results
3.6. Antibacterial Tests
4. Conclusions
Author Contributions
Funding
Acknowledgments
Conflicts of Interest
References
- Giavaresi, G.; Meani, E.; Sartori, M.; Ferrari, A.; Bellini, D.; Sacchetta, A.C.; Meraner, J.; Sambri, A.; Vocale, C.; Sambri, V. Efficacy of antibacterial-loaded coating in an in vivo model of acutely highly contaminated implant. Int. Orthop. 2014, 38, 1505–1512. [Google Scholar] [CrossRef] [PubMed]
- Russotto, V.; Cortegiani, A.; Raineri, S.M.; Giarratano, A. Bacterial contamination of inanimate surfaces and equipment in the intensive care unit. J. Intensive Care 2015, 3, 54. [Google Scholar] [CrossRef]
- Montazer, M.; Shamei, A.; Alimohammadi, F. Stabilized nanosilver loaded nylon knitted fabric using BTCA without yellowing. Prog. Org. Coat. 2012, 74, 270–276. [Google Scholar] [CrossRef]
- Wang, M.; Zhang, M.; Pang, L.; Yang, C.; Zhang, Y.; Hu, J.; Wu, G. Fabrication of highly durable polysiloxane-zinc oxide (ZnO) coated polyethylene terephthalate (PET) fabric with improved ultraviolet resistance, hydrophobicity, and thermal resistance. J. Colloid Interf. Sci. 2019, 537, 91–100. [Google Scholar] [CrossRef]
- Neely, A.N.; Orloff, M.M. Survival of some medically important fungi on hospital fabrics and plastics. J. Clin. Microbiol. 2001, 39, 3360–3361. [Google Scholar] [CrossRef] [PubMed]
- Neely, A.N.; Maley, M.P. Survival of enterococci and staphylococci on hospital fabrics and plastic. J. Clin. Microbiol. 2000, 38, 724–726. [Google Scholar]
- Augustine, R.; Kalarikkal, N.; Thomas, S. Electrospun PCL membranes incorporated with biosynthesized silver nanoparticles as antibacterial wound dressings. Appl. Nanosci. 2016, 6, 337–344. [Google Scholar] [CrossRef]
- Lim, J.P.; Baeg, G.H.; Srinivasan, D.K.; Dheen, S.T.; Bay, B.H. Potential adverse effects of engineered nanomaterials commonly used in food on the miRNome. Food Chem. Toxicol. 2017, 109, 771–779. [Google Scholar] [CrossRef]
- Jemat, A.; Ghazali, M.; Razali, M.; Otsuka, Y.; Rajabi, A. Effects of TiO2 on microstructural, mechanical properties and in-vitro bioactivity of plasma sprayed yttria stabilised zirconia coatings for dental application. Ceram. Int. 2018, 44, 4271–4281. [Google Scholar] [CrossRef]
- Zhu, Y.; Wang, Y.; Sha, L.; Zhao, J. Preparation of antimicrobial fabric using magnesium-based PET masterbatch. Appl. Surf. Sci. 2017, 425, 1101–1110. [Google Scholar] [CrossRef]
- Shahidi, S.; Moazzenchi, B. The Influence of Dyeing on the Adsorption of Silver and Copper Particles as Antibacterial Agents on to Cotton Fabrics. J. Nat. Fibers 2018, 1–11. [Google Scholar] [CrossRef]
- Pelgrift, R.Y.; Friedman, A.J. Nanotechnology as a therapeutic tool to combat microbial resistance. Adv. Drug Deliv. Rev. 2013, 65, 1803–1815. [Google Scholar] [CrossRef] [PubMed]
- Malachová, K.; Praus, P.; Rybková, Z.; Kozák, O. Antibacterial and antifungal activities of silver, copper and zinc montmorillonites. Appl. Clay Sci. 2011, 53, 642–645. [Google Scholar] [CrossRef]
- Eremenko, A.; Petrik, I.; Smirnova, N.; Rudenko, A.; Marikvas, Y. Antibacterial and antimycotic activity of cotton fabrics, impregnated with silver and binary silver/copper nanoparticles. Nano. Res. Lett. 2016, 11, 28. [Google Scholar] [CrossRef] [PubMed]
- Mahmoudi, E.; Ang, W.L.; Ng, C.Y.; Ng, L.Y.; Mohammad, A.W.; Benamor, A. Distinguishing characteristics and usability of graphene oxide based on different sources of graphite feedstock. J. Colloid Interf. Sci. 2019, 542, 429–440. [Google Scholar] [CrossRef] [PubMed]
- Zhang, Y.; Xu, Q.; Fu, F.; Liu, X. Durable antimicrobial cotton textiles modified with inorganic nanoparticles. Cellulose 2016, 23, 2791–2808. [Google Scholar] [CrossRef]
- Pal, A.; Sung, B.; Prasad, B.A.B.; Schuber, P.T.; Prasad, S.; Aggarwal, B.B.; Bornmann, W.G. Curcumin glucuronides: Assessing the proliferative activity against human cell lines. Bioorg. Med. Chem. 2014, 22, 435–439. [Google Scholar] [CrossRef]
- Tian, H.; Zhang, Z.-Y.; Liu, C.-Y. Construction of needle-like crystalline AgO ordered structures from Ag nanoparticles and their properties. New J. Chem. 2018, 42, 5376–5381. [Google Scholar] [CrossRef]
- Yoo, J.-Y.; Jang, E.-Y.; Jeong, S.-Y.; Hwang, D.-Y.; Son, H.-J. Bacterial indoleacetic acid-induced synthesis of colloidal Ag2O nanocrystals and their biological activities. Bioprocess Biosyst. Eng. 2018, 1–14. [Google Scholar] [CrossRef]
- Rajabi, A.; Ghazali, M.J.; Mahmoudi, E.; Azizkhani, S.; Sulaiman, N.; Mohammad, A.; Mustafah, N.M.; Ohnmar, H.; Naicker, A. Development and antibacterial application of nanocomposites: Effects of molar ratio on Ag2O–CuO nanocomposite synthesised via the microwave-assisted route. Ceram. Int. 2018, 44, 21591–21598. [Google Scholar] [CrossRef]
- Mahmoudi, E.; Ng, L.Y.; Ang, W.L.; Chung, Y.T.; Rohani, R.; Mohammad, A.W. Enhancing Morphology and Separation Performance of Polyamide 6, 6 Membranes By Minimal Incorporation of Silver Decorated Graphene Oxide Nanoparticles. Sci. Rep. 2019, 9, 1216. [Google Scholar] [CrossRef] [PubMed]
- Sasidharan, M.; Nakashima, K. Core–shell–corona polymeric micelles as a versatile template for synthesis of inorganic hollow nanospheres. Accounts Chem. Res. 2013, 47, 157–167. [Google Scholar] [CrossRef] [PubMed]
- Anandan, S.; Lee, G.-J.; Wu, J.J. Sonochemical synthesis of CuO nanostructures with different morphology. Ultrason. Sonochem. 2012, 19, 682–686. [Google Scholar] [CrossRef] [PubMed]
- Bang, J.H.; Suslick, K.S. Applications of ultrasound to the synthesis of nanostructured materials. Adv. Mater. 2010, 22, 1039–1059. [Google Scholar] [CrossRef]
- Xu, H.; Zeiger, B.W.; Suslick, K.S. Sonochemical synthesis of nanomaterials. Chem. Soc. Rev. 2013, 42, 2555–2567. [Google Scholar] [CrossRef] [Green Version]
- Raj, B.G.S.; Kim, H.-Y.; Kim, B.-S. Ultrasound assisted formation of Mn2SnO4 nanocube as electrodes for high performance symmetrical hybrid supercapacitors. Electrochim. Acta 2018, 278, 93–105. [Google Scholar]
- Zhao, B.; Lu, M.; Wang, Z.; Jiao, Z.; Hu, P.; Gao, Q.; Jiang, Y.; Cheng, L. Self-assembly of ultrathin MnO2/graphene with three-dimension hierarchical structure by ultrasonic-assisted co-precipitation method. J. Alloy. Compd. 2016, 663, 180–186. [Google Scholar] [CrossRef]
- Jimmy, C.Y.; Yu, J.; Ho, W.; Zhang, L. Preparation of highly photocatalytic active nano-sized TiO2 particles via ultrasonic irradiation. Chem. Commun. 2001, 1942–1943. [Google Scholar] [CrossRef]
- Abiraman, T.; Ramanathan, E.; Kavitha, G.; Rengasamy, R.; Balasubramanian, S. Synthesis of chitosan capped copper oxide nanoleaves using high intensity (30 kHz) ultrasound sonication and their application in antifouling coatings. Ultrason. Sonochem. 2017, 34, 781–791. [Google Scholar] [CrossRef]
- Jin, Z.-L.; Kim, N.-H. RAD51 maintains chromosome integrity and mitochondrial distribution during porcine oocyte maturation in vitro. J. Reprod. Develop. 2017, 63, 489–496. [Google Scholar] [CrossRef] [Green Version]
- Rajabi, A.; Ghazali, M.J. Quantitative analyses of TiC nanopowders via mechanical alloying method. Ceram. Int. 2017, 43, 14233–14243. [Google Scholar] [CrossRef]
- Sulaiman, N.; Ghazali, M.J.; Yunas, J.; Rajabi, A.; Majlis, B.Y.; Razali, M. Synthesis and characterization of CaFe2O4 nanoparticles via co-precipitation and auto-combustion methods. Ceram. Int. 2018, 44, 46–50. [Google Scholar] [CrossRef]
- Chakraborty, S.; Chelli, V.R.; Das, R.K.; Giri, A.S.; Golder, A.K. Bio-mediated silver nanoparticle synthesis: Mechanism and microbial inactivation. Toxicol. Environ. Chem. 2017, 99, 434–447. [Google Scholar] [CrossRef]
- Thi, V.H.T.; Lee, B.-K. Development of multifunctional self-cleaning and UV blocking cotton fabric with modification of photoactive ZnO coating via microwave method. J. Photochem. Photobiol. A Chem. 2017, 338, 13–22. [Google Scholar]
- Ates, E.S.; Unalan, H.E. Zinc oxide nanowire enhanced multifunctional coatings for cotton fabrics. Thin Solid Films 2012, 520, 4658–4661. [Google Scholar] [CrossRef]
- Saffari, J.; Mir, N.; Ghanbari, D.; Khandan-Barani, K.; Hassanabadi, A.; Hosseini-Tabatabaei, M.R. Sonochemical synthesis of Fe3O4/ZnO magnetic nanocomposites and their application in photo-catalytic degradation of various organic dyes. J. Mater. Sci. 2015, 26, 9591–9599. [Google Scholar]
- Kai, X.; Tian, K.; Wang, C.; Jiao, L.; Chen, G.; Zhao, Y. Effects of ultrasonic vibration on the microstructure and tensile properties of the nano ZrB2/2024Al composites synthesized by direct melt reaction. J. Alloys Compd. 2016, 668, 121–127. [Google Scholar] [CrossRef]
- Zeiger, B.W.; Suslick, K.S. Sonofragmentation of molecular crystals. J. Am. Chem. Soc. 2011, 133, 14530–14533. [Google Scholar] [CrossRef]
- Zhang, Z.P.; Rong, M.Z.; Zhang, M.Q.; Yuan, C.E. Alkoxyamine with reduced homolysis temperature and its application in repeated autonomous self-healing of stiff polymers. Polym. Chem. 2013, 4, 4648–4654. [Google Scholar] [CrossRef]
- Jiang, J.; Wan, F.; Yang, J.; Hao, W.; Wang, Y.; Yao, J.; Shao, Z.; Zhang, P.; Chen, J.; Zhou, L. Enhancement of osseointegration of polyethylene terephthalate artificial ligament by coating of silk fibroin and depositing of hydroxyapatite. Int. J. Nanomed. 2014, 9, 4569. [Google Scholar] [CrossRef]
- Li, W.D.; Ding, E.Y. Preparation and characterization of poly (ethylene terephthalate) fabrics treated by blends of cellulose nanocrystals and polyethylene glycol. J. Appl. Polym. Sci. 2007, 105, 373–378. [Google Scholar] [CrossRef]
- Rokade, A.A.; Patil, M.P.; Yoo, S.I.; Lee, W.K.; Park, S.S. Pure green chemical approach for synthesis of Ag2O nanoparticles. Green Chem. Lett. Rev. 2016, 9, 216–222. [Google Scholar] [CrossRef]
- Tian, Y.; Jiang, L. Wetting: Intrinsically robust hydrophobicity. Nat. Mater. 2013, 12, 291. [Google Scholar] [CrossRef]
- Kim, K.; Lichtenhan, J.D.; Otaigbe, J.U. Facile route to nature inspired hydrophobic surface modification of phosphate glass using polyhedral oligomeric silsesquioxane with improved properties. Appl. Surf. Sci. 2018, 470, 733–743. [Google Scholar] [CrossRef]
- Feng, B.; Weng, J.; Yang, B.; Qu, S.; Zhang, X. Characterization of surface oxide films on titanium and adhesion of osteoblast. Biomaterials 2003, 24, 4663–4670. [Google Scholar] [CrossRef]
- Kim, B.H.; Lee, D.H.; Kim, J.Y.; Shin, D.O.; Jeong, H.Y.; Hong, S.; Yun, J.M.; Koo, C.M.; Lee, H.; Kim, S.O. Mussel-inspired block copolymer lithography for low surface energy materials of teflon, graphene, and gold. Adv. Mater. 2011, 23, 5618–5622. [Google Scholar] [CrossRef]
- Suryaprabha, T.; Sethuraman, M.G. Fabrication of copper-based superhydrophobic self-cleaning antibacterial coating over cotton fabric. Cellulose 2017, 24, 395–407. [Google Scholar] [CrossRef]
- Wang, X.; Wu, H.-F.; Kuang, Q.; Huang, R.-B.; Xie, Z.-X.; Zheng, L.-S. Shape-dependent antibacterial activities of Ag2O polyhedral particles. Langmuir 2009, 26, 2774–2778. [Google Scholar] [CrossRef]
- Liu, B.; Mu, L.; Han, B.; Zhang, J.; Shi, H. Fabrication of TiO2/Ag2O heterostructure with enhanced photocatalytic and antibacterial activities under visible light irradiation. Appl. Surf. Sci. 2017, 396, 1596–1603. [Google Scholar] [CrossRef]
- D’alessandro, A.; Nemkov, T.; Hansen, K.C.; Szczepiorkowski, Z.M.; Dumont, L.J. Red blood cell storage in additive solution-7 preserves energy and redox metabolism: A metabolomics approach. Transfusion 2015, 55, 2955–2966. [Google Scholar]
- Syed, M.; Skonberg, C.; Hansen, S.H. Inhibition of ATP synthesis by fenbufen and its conjugated metabolites in rat liver mitochondria. Toxicol. In Vitro 2016, 31, 23–29. [Google Scholar] [CrossRef]
- Lakshmi Prasanna, V.; Vijayaraghavan, R. Insight into the mechanism of antibacterial activity of ZnO: Surface defects mediated reactive oxygen species even in the dark. Langmuir 2015, 31, 9155–9162. [Google Scholar] [CrossRef]
- Allahverdiyev, A.M.; Abamor, E.S.; Bagirova, M.; Rafailovich, M. Antimicrobial effects of TiO2 and Ag2O nanoparticles against drug-resistant bacteria and leishmania parasites. Future Microbiol. 2011, 6, 933–940. [Google Scholar] [CrossRef]
- Wang, X.; Li, S.; Yu, H.; Yu, J.; Liu, S. Ag2O as a New Visible-Light Photocatalyst: Self-Stability and High Photocatalytic Activity. Chem. Eur. J. 2011, 17, 7777–7780. [Google Scholar] [CrossRef]

| Sample Label | Description |
|---|---|
| F1 | Ag2O-coated PET fabric synthesized at pH 6.5 |
| F2 | Ag2O-coated PET fabric synthesized at pH 7.5 |
| F3 | Ag2O-coated PET fabric synthesized at pH 8.5 |
| F4 | Ag2O-coated PET fabric synthesized at pH 9.5 |
| F5 | Ag2O-coated PET fabric synthesized at pH 10.5 |
| Wavenumber (cm−1) | Vibration Characteristics | Wavenumber (cm−1) | Vibration Characteristics |
|---|---|---|---|
| 3339 | –H bonded OH stretch | 1339 | N–O stretching |
| 2874 | C–H2 groups | 1247 | C–O) vibrations |
| 2361 | C–H2 groups | 1098 | (C–O) vibrations |
| 1712 | carbonyl (C=O) stretching | 1018 | (C–O) vibrations |
| 1560 | phenyl groups | 650–900 | benzene rings |
| 1408 | methylene groups |
| Sample Label | Inhibition Zone Diameter (mm) |
|---|---|
| F1 | 11 ± 0.3 |
| F2 | 13 ± 0.1 |
| F3 | 14 ± 0.2 |
| F4 | 12 ± 0.3 |
| F5 | 11 ± 0.3 |
© 2019 by the authors. Licensee MDPI, Basel, Switzerland. This article is an open access article distributed under the terms and conditions of the Creative Commons Attribution (CC BY) license (http://creativecommons.org/licenses/by/4.0/).
Share and Cite
Rajabi, A.; Ghazali, M.J.; Mahmoudi, E.; Baghdadi, A.H.; Mohammad, A.W.; Mustafah, N.M.; Ohnmar, H.; Naicker, A.S. Synthesis, Characterization, and Antibacterial Activity of Ag2O-Loaded Polyethylene Terephthalate Fabric via Ultrasonic Method. Nanomaterials 2019, 9, 450. https://doi.org/10.3390/nano9030450
Rajabi A, Ghazali MJ, Mahmoudi E, Baghdadi AH, Mohammad AW, Mustafah NM, Ohnmar H, Naicker AS. Synthesis, Characterization, and Antibacterial Activity of Ag2O-Loaded Polyethylene Terephthalate Fabric via Ultrasonic Method. Nanomaterials. 2019; 9(3):450. https://doi.org/10.3390/nano9030450
Chicago/Turabian StyleRajabi, Armin, Mariyam Jameelah Ghazali, Ebrahim Mahmoudi, Amir Hossein Baghdadi, Abdul Wahab Mohammad, Nadia Mohd Mustafah, Htwe Ohnmar, and Amaramalar Selvi Naicker. 2019. "Synthesis, Characterization, and Antibacterial Activity of Ag2O-Loaded Polyethylene Terephthalate Fabric via Ultrasonic Method" Nanomaterials 9, no. 3: 450. https://doi.org/10.3390/nano9030450






